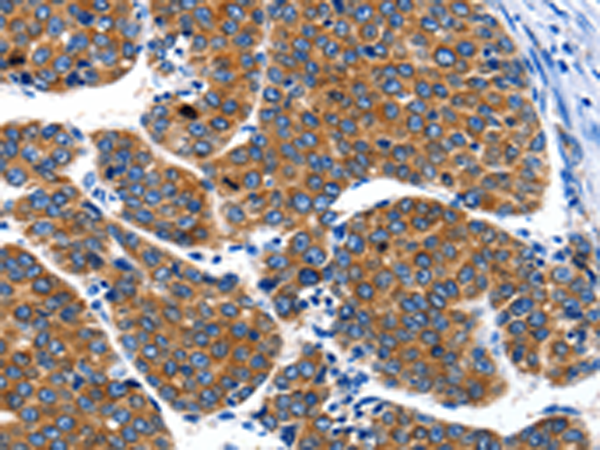
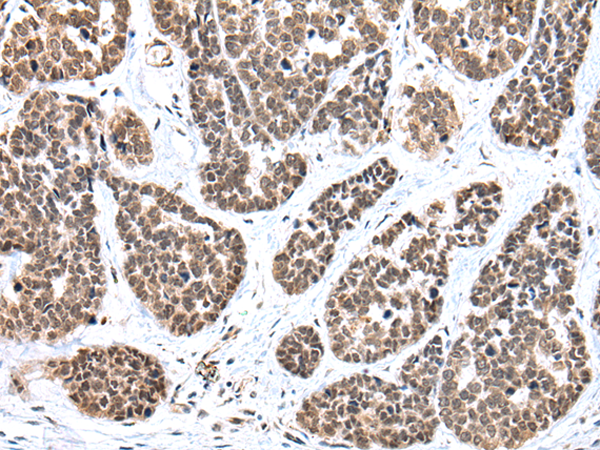
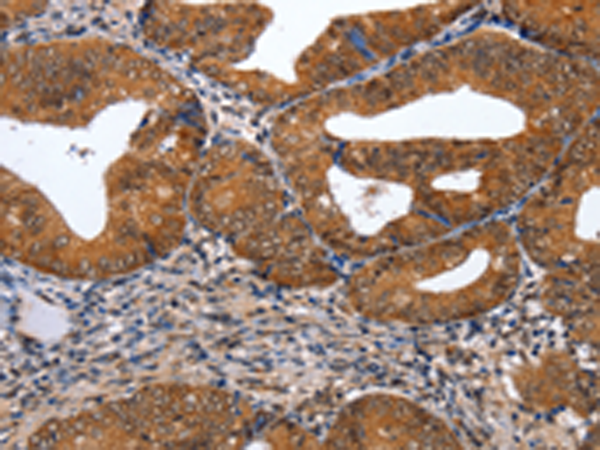

-
分类: 科研抗体货号: P10895别名: CKLFSF2应用: WB反应种属: Human
-
分类: 科研抗体货号: P10875别名: IMP1, ZBP1, CRDBP, IMP-1, CRD-BP, VICKZ1应用: WB,IHC反应种属: Human, Mouse, Rat
-
分类: 科研抗体货号: P10893别名: CKLFSF8; CKLFSF8-V2应用: IHC反应种属: Human, Mouse
-
分类: 科研抗体货号: P10874别名: FS应用: IHC反应种属: Human, Mouse, Rat
-
分类: 科研抗体货号: P10892别名: CKLFSF6; PRO2219应用: WB,IHC反应种属: Human
-
分类: 科研抗体货号: P10873别名: JM2, AIID, IPEX, PIDX, XPID, DIETER应用: WB反应种属: Human, Mouse
-
分类: 科研抗体货号: P10891别名: CKLFSF5应用: WB反应种属: Human, Mouse
-
分类: 科研抗体货号: P10871别名: MFH; QRF1; 12CC4; hFKH1B; HSPC215应用: IHC反应种属: Human, Mouse, Rat
-
分类: 科研抗体货号: P10890别名:应用: IHC反应种属: Human, Mouse, Rat
-
分类: 科研抗体货号: P10869别名: HTLF应用: WB,IHC反应种属: Human

鄂公网安备42018502007531号
鄂公网安备42018502007531号

